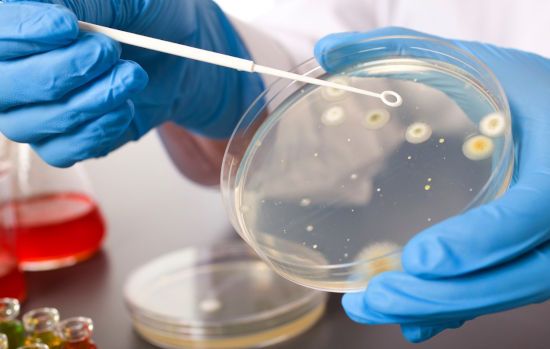

В норме легкие — самоочищающаяся система и способны справляться с последствиями загрязнений, поступивших из внешней среды. Однако если мы подвергаем из опасному воздействую постоянно — например, во время активного или пассивного курения или вдыхая загрязненный воздух — легкие просто не успевают выводить опасную слизь. Мокрота, скапливающаяся внутри наших органов дыхания, привлекает бактерии и другие патогенные микроорганизмы, которые в свою очередь могут способствовать развитию различных заболеваний, в том числе и очень опасных. Если вы или ваши близкие курят (и вы постоянно вдыхаете сигаретный дым), живете в городе с загрязненным воздухом, используете токсичные вещества во время работы или домашних дел, возможно, вам стоит помочь своим легким. Рассказываем, как можно очистить органы дыхания в домашних условиях и сделать их более здоровыми и выносливыми.
О чем говорит вид слизи?
Характер слизи тоже может быть разный — запах, консистенция, цвет могут существенно отличаться. И по этим признакам можно судить о том или ином недуге:
- Бесцветная и вязкая – бывает после приступа бронхоспазма
- Гнойная (слизь густая, желтоватого цвета, иногда присутствует неприятный запах, часто бывает при кашле) говорит о бронхите, муковисцидозе, трахеите. При наличии такой слизи бывает очень трудно откашляться
- Кровянистая (с вкраплением прожилок крови). Она свидетельствует о легочном кровотечении
- Белая – такая мокрота может проявляться, если у человека есть кандидоз дыхательных путей. От подобного симптома очень непросто избавиться. При этом может быть кашель
- Стекловидная (мокрота густая и тягучая, при этом абсолютно прозрачная). Такая слизь в горле не отхаркивается
- Очень обильная слизь, которая имеет плохой запах, может говорить о таком грозном недуге, как абсцесс легкого
Кашель с мокротой
Примерно у трети больных коронавирусом он сразу проявляется влажным кашлем, при котором отходит мокрота. Это рефлекторная защитная реакция организма, помогающая очиститься респираторным путям. Но медики обнаружили, что чаще всего влажный кашель возникает у людей с изначальными поражениями органов дыхательной системы. В процессе репликации коронавирусы выделяют в окружающее пространство токсичные продукты своей жизнедеятельности. Их распространение по организму провоцирует обострение хронических бронхолегочных патологий.
Также влажный кашель отмечался у таких групп пациентов:
- курильщиков;
- предрасположенных к развитию аллергических реакций.
У большинства же инфицированных мокрота начинает отходить после приема препаратов для ее разжижения. Уменьшается вязкость бронхиального секрета, ускоряется его эвакуация из дыхательных путей. Густая слизь, прочно прикрепленная к бронхам, гортани, глотке разжижается. Одновременно рассасываются воспалительные отеки, которые затрудняли циркуляцию воздуха. Увеличивается и подвижность ресничек, покрывающих эпителий. Выздоровление также ускоряется и за счет быстрого транспорта коронавирусов мукоцилиарной системой.
Какие заболевания вызывают появление мокроты?
Скопление слизи в горле сигнализирует заболеваниях:
- респираторной инфекции
- хроническом рините
- фарингите
- тонзиллите
- ларингите
- гайморите
- трахеите
- бронхите
- астме
Как правило, острые стадии этих недугов сопровождаются и прочими признаками. Помимо того густая мокрота в горле не отходит, присутствуют еще и жар, боль, кашель из за слизи в носоглотке, общее недомогание. Но при хроническом течении заболевания комок слизи в носоглотке может быть единственным признаком недуга, у такой мокроты часто присутствует неприятный запах.
Постуральный дренаж
Эти упражнения подходят в том числе для тех пациентов, у которых начинаются проблемы с дыханием — одышка, затрудненное дыхание. Разумеется, в таких случаях нужно сразу вызывать врача, но до его прихода можно помочь себе или близкому с помощью приведенных ниже упражнений.
Лежа на спине:
- Лягте на пол или на кровать;
- Положите подушки под бедра так, чтобы грудь была ниже, чем бедра;
- Медленно вдохните воздух через нос и выдохните через рот. Каждый выдох должен занимать вдвое больше времени, чем вдох.
- Повторяйте в течение нескольких минут.
Лежа на боку:
- Лягте на бок, положив голову на руку или подушку;
- Положите подушки под бедра;
- Медленно вдохните воздух через нос и выдохните через рот. Каждый выдох должен занимать вдвое больше времени, чем вдох.
- Повторяйте в течение нескольких минут, после чего повторите, повернувшись на другой бок.
Лежа на животе
- Положите стопку подушек на пол;
- Лягте животом на подушки так, чтобы бедра были выше груди;
- Положите руки под голову для поддержки;
- Медленно вдохните воздух через нос и выдохните через рот. Каждый выдох должен занимать вдвое больше времени, чем вдох.
- Повторяйте в течение нескольких минут.
(
Лекарства от мокроты в горле
Лечение подобного состояния нужно начинать с устранения причины. Мокрота в горле, причины которой кроются в наличии инфекционных заболеваний, в первую очередь требует лечения именно этих болезней. Поэтому лечение мокроты, которая долго не проходит носит комплексный характер.
Чтобы избавиться от мокроты назначают следующее:
- Муколитики (Аброл, Лазолван, Пектолван), особенно если присутствует кашель
- Полоскание горла растворами антисептических препаратов, Мирамистин, Стоматидин
- Укреплять местный иммунитет – в этом помогут ИРС -19, Лизобакт
- Пастилки с растительными компонентами – Доктор Мом, Трависил, Стопангин помогут убрать кашель и раздражение в горле
- Орошение горла лекарственными растворами – Хепилором, Каметоном, Хлорофиллиптом. Их нужно делать обязательно
- При кашле хорошо применять ингаляции с небулайзером. В качестве лекарств используют средства, разжижающие мокроту. Лечение очень эффективно, особенно, если кашель хронический
Диагностика
Пациент с жалобами на вязкую мокроту проходит комплексное обследование у врача-пульмонолога. Ценную информацию дают физикальные методы обследования: пальпация (болезненность грудной клетки), перкуссия (локальные зоны притупления, коробочный звук), аускультация (влажные хрипы разного калибра, ослабленное дыхание, бронхофония). Диагностический план включает следующие лабораторные и инструментальные методы:
- Рентгенография.
Стандартная рентгенограмма ОГК проводится, чтобы обнаружить локальную патологию — очаги инфильтрации или распада легочной ткани, признаки аномалий развития. Дополнительно выполняется рентгеноскопия. Чтобы детально рассмотреть структуру органов грудной клетки, необходима компьютерная томография. - Спирометрия.
Исследование функции внешнего дыхания показывает снижение ОФВ1, признаки дыхательных нарушений обструктивного или рестриктивного типа. Для дифференцировки между ХОБЛ и бронхиальной астмой ставится тест с сальбутамолом, по результатам которого оценивают степень обратимости обструкции. - Инвазивные исследования.
Для осмотра внутренней поверхности бронхов, выявления признаков воспалительного процесса, забора образцов слизи проводится бронхоскопия. Чтобы оценить структуру бронхиального дерева, диагностировать хронический бронхит и бронхоэктазы, делают бронхографию с контрастным веществом. - Анализ мокроты.
При микроскопии слизь содержит большое количество нейтрофилов (при инфекционном воспалении), кристаллы Шарко-Лейдена и спирали Куршмана (при бронхиальной астме). Для уточнения этиологии патологического процесса производится бактериологический посев полученного секрета. - Дополнительные лабораторные методы.
Типичные отклонения в гемограмме: лейкоцитоз со сдвигом влево при бактериальной инфекции, лимфоцитоз при вирусных возбудителях, эозинофилия — при аллергических заболеваниях легких. В биохимии крови определяют острофазовые показатели, уровень IgE. Иногда назначается расширенная иммунограмма.
При аускультации легких выслушиваются влажные хрипы разного калибра
Другие методы лечения
Если причиной подобного явления стал гипертрофический фарингит, то лечение будет заключаться в смазывании горла растворами протаргола, колларгола, Люголя. В самых тяжелых случаях возможно лечение с помощью криотерапии.
Иногда лечение мокроты, особенно, если есть бактериальная инфекция, не может обойтись без антибиотиков. Такие лекарства часто назначают при кашле. Но и при воспалениях верхних дыхательных путей, если другие методы не помогают, назначают антибактериальную терапию. Рекомендуют пить щелочную воду и не употреблять продукты, которые могут раздражать слизистую горла.
Разновидности
На то, что взрослый или ребенок идет на поправку указывает отделение прозрачной мокроты. Если она отходит с трудом при надрывистом кашле, окрашена в какой-либо цвет, неприятно пахнет, то высок риск развития осложнений. Следует незамедлительно сообщить врачу о появлении такого слизистого секрета.
С кровью
Примеси свежей крови в мокроте при коронавирусной инфекции появляются исключительно редко. Обычно наблюдаются редкие темно-коричневые кровяные прожилки, что служит специфическим признаком тяжелого поражения нижних дыхательных путей болезнетворными бактериями. Могут активизироваться на фоне ослабления иммунитета уже присутствующие условно-патогенные микробы, или патогены проникают в организм извне. Под воздействием вырабатываемых ими токсинов повышается проницаемость сосудов, питающих кровью легочные структуры.
Это сопровождается практически всегда такими симптомами:
- лихорадочным состоянием, ознобом;
- затрудненным дыханием;
- болями в грудной клетке.
Если при откашливании выделяется скудная мокрота с кровяными прожилками, примесями свежей крови, то пневмония или развилась, или возникнет совсем скоро.
Выделения с кровью часто указывают на присоединение к коронавирусу бактериальной инфекции
Важно! При смешанной вирусно-бактериальной инфекции при откашливании отделяется коричневая слизисто-гнойная на 2-3 день пневмонии. На КТ отчетливо визуализируется эффект «матового стекла» — неспецифический симптом, отражающий различные патологические изменения в легких на уровне альвеол.
Зеленая
Обильная или скудная зеленая мокрота является тревожным сигналом, характеризующим поражение верхних и нижних дыхательных путей. Это признак попадания в них большого количества болезнетворных бактерий: стафилококков, стрептококков, пневмококков. Зеленый цвет густой слизи объясняется наличием в ней погибших патогенных микроорганизмов и продуктов остро протекающего инфекционно-воспалительного процесса.
Как правило, при отхождении вязкой зеленоватой-коричневой мокроты человек с коронавирусом незамедлительно госпитализируется. Необходимо проведение интенсивной антибиотикотерапии для предупреждения бактериальной пневмонии. Кашель с зеленой мокротой часто сопряжен с дополнительными симптомами:
- высокой температурой;
- затрудненным дыханием;
- упадком сил.
Перед началом лечения будет проведен ряд биохимических исследований для установления видовой принадлежности инфекционных возбудителей и их чувствительности к антибиотикам. Для исключения онкологических патологий выполняется торакоскопия.
Желтая
Слизь желтого цвета также указывает на наличие в организме патогенов и нередко свидетельствует о начавшемся абсцессе легкого. Так называется неспецифическое воспаление легочной ткани, в результате которого происходит расплавление с образованием гнойно-некротических полостей. Для тяжелой патологии характерно отхождение желтоватой зловонной мокроты во время прорыва абсцесса в дренирующие бронхи. А происходит это всегда внезапно — сухой кашель стремительно сменяется влажным с последующим отхаркиванием большого объема жидких гнойных выделений «полным ртом».
Появление желтой мокроты может быть признаком тяжелейшего осложнения коронавируса — абсцесса легких
После отхождения мокроты самочувствие быстро улучшается, нормализуется температура тела, исчезают признаки интоксикации. Но врачебное вмешательство жизненно необходимо. Лечение в основном медикаментозное — антибиотиками, отхаркивающими препаратами, бронходилататорами и гормонами. По показаниям могут проводиться хирургические операции.
Применение народной медицины
Лечение патологии редко обходится без народных способов, которые использовали еще наши бабушки. Особенно, если все стандартные виды терапии уже использованы. Что же делать, как избавиться от мокроты, чтобы облегчить свое состояние?
Вот некоторые рецепты, которые помогут при постоянной мокроте в носоглотке:
- Скопление слизи в горле можно убрать, если мелко порезать лист алоэ, добавить к нему столовую ложку меда и принимать натощак — алоэ с медом
- Что делать, если мокрота вязкая и плохо отходит? Нужно взять 30 г прополиса, измельчить его и залить 100 мл спирта. Настойку убрать в темное место и взбалтывать каждый день. Через неделю процедить, добавить эфирное масло персика (50 мл). Этой смесью нужно очень тщательно смазывать слизистую оболочку носоглотки утром и вечером
- Избавиться от мокроты поможет такое лечение. Смешайте в равных пропорциях траву шалфея, эвкалипта, календулы и ромашки. 1 ст. л. смеси запарьте в термосе стаканом воды. Через два часа процедите, остудите и добавьте чайную ложку меда. Этим раствором полощите горло 4 раза в день. Лекарство очень скоро облегчит ваше состояние
- Убрать комок в горле поможет полоскание морской солью. Чайную ложку соли растворите в 0,5 л теплой воды и прополощите горло (можно промыть и нос). Чтобы быстро избавиться от слизи, повторять процедуру нужно трижды в день
- Если в горле скапливается вязкая мокрота, которую тяжело отхаркнуть, то помогут ингаляции с содой. Пар должен быть не слишком горячим, чтобы не обжечь горло
Почему постоянное количество мокроты в горле требует незамедлительной консультации специалиста? Ведь она может говорить о серьезных патологиях в организме. Ее вид и запах могут рассказать о причинах заболевания. После обследования врач назначит лечение и выздоровление не заставит себя ждать.
Как вывести мокроту у курильщика
Дыхательная система курильщика изнашивается гораздо быстрее. Вещества, содержащиеся в табачном дыме и никотин, раздражают лёгкие, провоцируют воспалительный процесс и оседают на альвеолах. И даже если вы бросите курить, избавиться от вредных веществ будет не так-то просто. Конечно, лёгкие будут очищаться самостоятельно, но на это может уйти большое количество времени (от нескольких лет, до десятилетия).
Быстрее вывести мокроту из бронхов и улучшить здоровье лёгких, помогут следующие способы.
Очищающие ингаляции
Благодаря паровым ингаляциям реснички эпителия активнее защищают бронхи и лёгкие от вредных веществ, происходит разжижение мокроты и выведение её из организма.
Для процедуры необходим ингалятор или небулайзер, в который заливаются солевой раствор, травяной отвар, минеральная вода или эфирное масло. Уже через месяц регулярного применения, начнут происходить изменения.
По началу вас может беспокоить сильный кашель со слизью и неприятный запах изо рта. Этот период нужно переждать, так легкие очищаются от смол и других вредных веществ. Дополнительно принимать лекарства от кашля не нужно, это затормозит процесс очищения.
Правила проведения ингаляций
- Процедуру проводят через 1-2 часа после приёма пищи.
- Параллельно нельзя использовать отхаркивающие средства.
- Аэрозоль вдыхается ртом, выдох происходит через нос.
- Длительность курса от 8 до 14 дней. После нужно сделать перерыв.
- Для ингаляций хорошо подходят масло эвкалипта, туи, сосны и пихты. На пол литра воды нужно не более 2-4 капель эфирного масла.
- Для травяных ингаляций лучше брать мяту, липу, дуб, чёрную смородину, ромашку или кору берёзы. На 500 мл воды добавляется 2 ст.л. травяного отвара.
Рецепт травяного отвара для отделения мокроты:
- Ромашка лекарственная – 25 г
- Листья первоцвета – 20 г
- Цветки бузины – 15 г
- Сосновые почки – 1 г
Соедините ингредиенты, добавьте 250 мл кипятка и варите на слабом огне 5-10 минут. Полученный отвар добавляйте по 2 ст.л. на пол литра воды для ингаляций.
Перед тем как начать очищающий курс, проконсультируйтесь с доктором.
Физическая нагрузка
Ускорить процесс очищения лёгких помогут занятия спортом. Когда вы активно двигаетесь, улучшается кровообращение, ваши органы быстрее насыщаются кислородом и полезными веществами. Это способствует выведению мокроты из бронхов и улучшает работу сердечно-сосудистой системы.
Пейте зелёный чай
Это напиток содержит большое количество антиоксидантов. Поэтому он хорошо защищает от вредного воздействия табачного дыма и помогает восстановить лёгкие. Кстати, в Китае было проведено исследование, которое показало, что люди, выпивающие по две чашки зелёного чая ежедневно, гораздо реже болеют раком лёгких.
Постуральный дренаж
Смысл процедуры заключается в том, что вы принимаете такое положение тела, которое способствует отхождению и выведению мокроты.
При этом, врач проводит различные манипуляции (поглаживает, постукивает и похлопывает по определённым участкам грудной клетки), которые способствуют перемещению застойной жидкости в главный бронх и трахею. А кашель окончательно удалит её из организма.
За одну такую процедуру может отойти до 200 мл мокроты. Единственный недостаток постурального дренажа, это то, что вы не сможете выполнить его самостоятельно.
Постуральный дренаж имеет несколько противопоказаний:
- Проблемы с сердцем
- Гипертония
- Заболевания головного мозга
- Острая пневмония
- Лёгочные кровотечения
- Травмы позвоночника
Повреждение рёбер
Есть альтернативный способ, который можно использовать дома. Для этого нужно сделать следующее:
- Примите положение лёжа на кровати или на полу.
- Чтобы верхняя часть туловища была ниже, положите под бёдра подушку.
- Начинайте дышать таким образом, чтобы выдох был в два раза короче вдоха. Дышим через нос, выдыхаем через рот. И так на протяжение 3-5 минут.
Как удалить слизь из бронхов с помощью лекарств
В фармацевтическом мире создано огромное количество препаратов, борющихся с кашлем и слизью в легких. Покупай и лечись? Не все так просто, каждое из лекарств имеет определенное воздействие на организм и отдельные структуры тканей.
Если рассматривать усредненный (стандартный) терапевтический курс очищения легких от слизи, он включает в себя:
Прием отхаркивающих средств. Такие лекарственные медикаменты уменьшают густоту слизи в легких, способствуют ее удалению и препятствуют всасывание организмом патогенной мокроты. За счет этого ускоряется выздоровление без риска обструкции (закупорки бронхов) и развития интоксикации.
Отхаркивающие средства подразделяются на две категории:
- Секретолики (рефлекторное воздействие) Такие медикаменты разжижают вязкую мокроту путем раздражения мускульной ткани бронхов. К ним относятся проверенные временем и распространенные растительные препараты на основе термопсиса, чабреца, корней алтея и солодки, грудные сборы.
- Муколитики, бронхолитики (прямое действие). Эти лекарства непосредственно воздействуют на свойства самой слизи. Активные компоненты препаратов разрывают белковые связи мокроты, разжижая ее. К лекарствам этой группы относят АЦЦ, Бромгексин, Амброксол.
Использование нетрадиционных методов лечения. Помимо медикаментов, медики рекомендуют дополнить лекарственный курс и разнообразными физиопроцедурами:
- ЛФК
- дыхательная гимнастика
- массаж
- посещение соляных комнат.
Немаловажное значение уделяется использованию народной медицины.
Препараты, выводящие мокроту из бронхов
Для эффективного лечения и достижения быстрого эффекта нужно знать основные лекарственные средства, которые помогут избавиться от скопления мокроты в легких. Применять их можно только после одобрения лечащего врача, так как каждое из них имеет ряд побочных эффектов и противопоказаний.
При сухом кашле на первое место выходят муколитики. Они переводят сухой кашель во влажный и снимают застойные явления в дыхательных путях.
К ним чаще всего относятся:
Нередко в этих случаях употребляются Амбробене и АЦЦ. Они являются препаратами комплексного действия, полностью устраняющими кашель, значительно облегчающими дыхание и заметно повышающими защитные силы организма.
Отхаркивающие лекарственные средства чаще используются при влажном кашле при бронхите. Они напрямую регулируют отделение мокроты из бронхов во внешнюю среду.
Одни из них действуют на центры головного мозга, другие — на слизистую оболочку дыхательных путей. Для этого применяются такие эффективные фармакологические средства, как:
- Термопсол
- Коделак
- Гербион
- Пертуссин
- Бронхикум
- Амброксол
- Бромгексин
Сиропы микстуры экстракты
Хороший результат оказывают различные сиропы и экстракты, в которых содержатся растительные вещества рефлекторного действия. К ним относится
- алтей
- барбарис
- термопсис
- семена укропа
- солодка
- мать-и-мачеха
- чабрец
- шалфей
- ромашка
Отличный эффект оказывает также ароматерапия с применением масла эвкалипта, ментола, чайного дерева. Они активно воздействуют прямо на бронхи пациента, оказывая позитивное влияние на них. Обычно они применяются при влажном кашле, когда нужно быстро облегчить выведение уже и так постепенно отходящей мокроты.
Фармакологическая промышленность выпускает специальные сиропы, микстуры и растворы для избавления от кашля и выведения избыточного секрета. К ним относится Геделикс, Доктор Мом и пр.
Все эти препараты оказывают эффективное действие в борьбе со скоплениями мокроты в бронхах. Они различны по своему назначению, дозировке и длительности курса лечения.
Эти средства имеют разную интенсивность воздействия на организм человека и его легочную систему. Также, все они дают возможность откашляться, вывести секрет из бронхов и снять их воспаление.